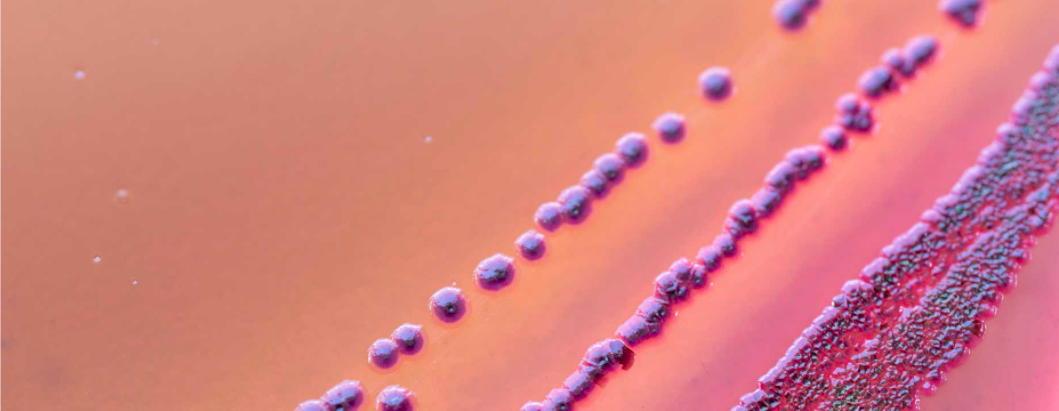
Screenshot 2021 11 02 At 10.39.10

Together for Antibiotics
Antibiotic resistance is a global health crisis. That’s why we’re #TogetherForAntibiotics
Drug resistant infections are on the rise: Around 1.2 million people across the world die from infections which are resistant to antibiotics every year.
These so called ‘superbugs’ are evolving all the time. If we don’t find new ways of stopping them, that number is estimated to rise to 10 million people a year in just three decades from now.
Around one in three patients in hospital rely on antibiotics to treat infections including those which can arise during or after surgery (such as hip and knee replacements and organ transplantations) or cancer chemotherapy treatment. Without antibiotics, treatment for many conditions would not be possible.
That’s why we must prioritise the search for new ones and protect the ones we have already.
This issue affects every person on the planet. Governments, healthcare systems and the pharmaceutical industry must team up to find new ways of discovering and paying for effective antibiotics.
AMR Briefing
If you are an MP or a Patient group you can download our briefing.


Share the facts
Download our free resources and share the facts about why #Togetherforantibiotics is important to all of us.
We’re Together For Antibiotics
We’re partnering with organisations and charities and working #TogetherForAntibiotics to raise awareness about the threat of, and solutions to, antibiotic resistance.
